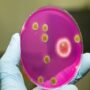
Носительство золотистого стафилококка

Очень важно постоянно следить за состоянием своего здоровья, ведь это самое важное, что есть у каждого человека.
Очень важно постоянно следить за состоянием своего здоровья, ведь это самое важное, что есть у каждого человека.
И порою один, пусть не очень серьезный на первый взгляд недуг, может спровоцировать развитие совершенно другой, более опасной болезни. Итальянские эксперты в ходе своих исследований выяснили, что сезонный грипп может дать толчок к такому серьезному заболеванию, как сахарный диабет 1 типа.
Еще в прошлом столетии ученые уже выдвигали гипотезу о том, что вирусы способны повлиять на зарождение диабета, и теперь эти предположения подтвердились.
Особенно опасен грипп сложной формы, который дает различные осложнения на нервную систему, легкие, мышцы, глаза, сердечно-сосудистую систему и пр. Вирусное заболевание ослабляет иммунитет человека, и тем самым увеличивает риск возникновения этих осложнений.
Грипп и диабет.
Если же человек уже болеет сахарным диабетом, то в таком случае при вирусных заболеваниях контролировать течение недуга становится гораздо сложнее. Ведь грипп для людей с повышенным сахаром намного опасней, чем для здоровых.
Это не только боль в мышцах, насморк и кашель, а еще и декомпенсация. Такое вирусное заболевание, поражающее мышцы и верхние дыхательные пути, чаще всего внезапно появляется и стремительно развивается. У человека, который заболел гриппом, наблюдается наличие следующих симптомов:
- высокая температура;
- лихорадочное состояние;
- общая слабость;
- боль в мышцах и в глазах;
- сухой кашель;
- покраснение и сухость кожи;
- боль в горле;
- выделения из носа;
- слезящиеся глаза.
При этом не обязательно все симптомы проявляются одновременно, могут присутствовать лишь некоторые из них. Как бы там ни было, но грипп накладывает на организм человека дополнительную стрессовую нагрузку. А это, в свою очередь, может привести к резким скачкам сахара в крови больного и развитию осложнений.
Также, человеку в таком состоянии иногда становится сложно принимать пищу, а это для диабетиков чревато гипогликемией. Многие медики настоятельно рекомендуют прививаться от гриппа, чтобы избежать скачков сахара, развития осложнений и декомпенсации диабета.
Но делать ее или нет – каждый человек решает лично. Единственное, что профилактика никогда не приносит вреда здоровью, а людям с ослабленным иммунитетом будет не лишним постараться хоть как-то себя обезопасить.
В таких целях можно носить стерильную марлевую повязку, стараться не контактировать с больными гриппом людьми, хорошо мыть руки после посещения больниц и прочих общественных мест.
Лечение гриппа при диабете
Если человеку не удалось обезопасить себя и он заболел гриппом, то очень важно придерживаться некоторых рекомендаций. Ни в коем случае и ни при каких обстоятельствах нельзя самовольно прекращать прием инсулина или сахароснижающих таблеток, даже при отсутствии аппетита.
Лечащий врач во время болезни может даже повысить для пациента дозы лекарств. Обязательно необходимо контролировать и регулировать свой уровень сахара и потреблять как можно больше жидкости. Лучше делать это небольшими дозами, чтобы не спровоцировать рвоту или диарею.
Питаться тоже нужно стараться полноценно и регулярно. Одним из явных признаков декомпенсации диабета является снижение веса, поэтому за этим тоже необходимо следить.
Прием лекарственных препаратов от гриппа диабетикам рекомендуется согласовывать с врачом, потому как подбором необходимого лечения должен заниматься профессионал. Но главное — помнить, что жидкие сиропы от гриппа и кашля, которые содержат сахар, в подобном случае противопоказаны.